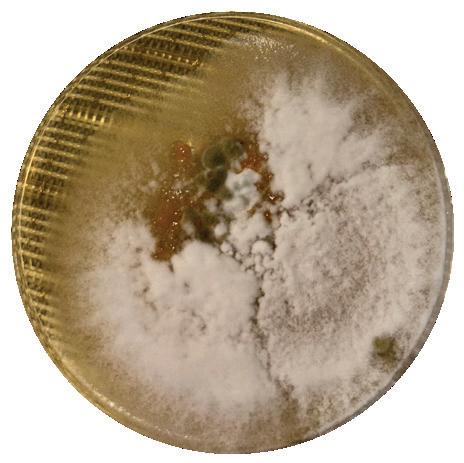
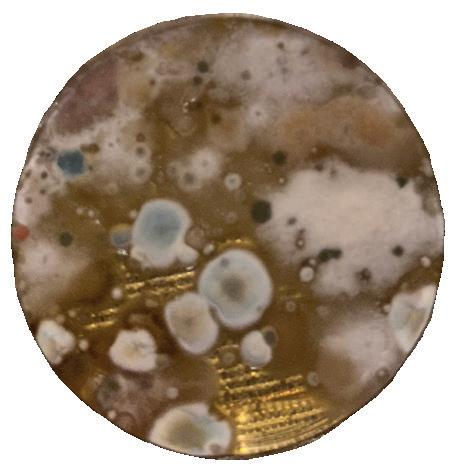
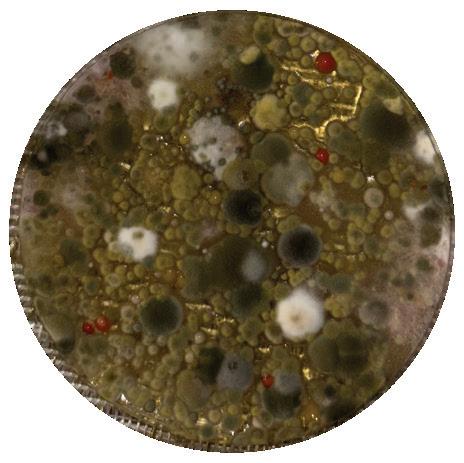
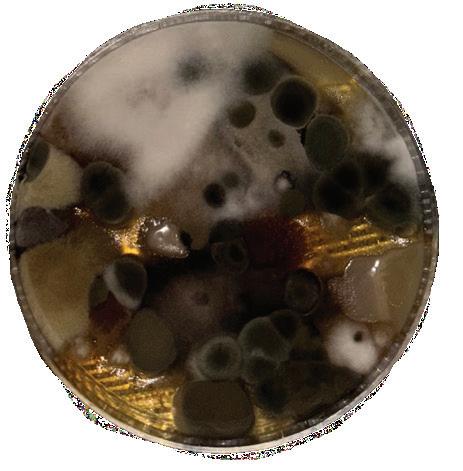

Women’s soccer secures spot in NCAA Division II Tournament

NATALIA LAGO beat reporter
The Harding women’s soccer team won the Great American Conference 2025 Women’s Soccer Championship Tournament on Sunday, Nov. 16. They played against Ouachita Baptist University and defeated them 1-0. With this, the women’s soccer team has earned the program’s first conference title in years and secured a spot in the NCAA Division II Tournament.
It was a tight game, as neither team scored a goal until the end of the first half. The match remained tense, with the weight of the championship title a mere 45 minutes away. The team was able to maintain their score and win the championship title.
This achievement has been in the works since 2016, and the team has been fine-tuning their strategies and working together to ensure they earned this title since then.
Coach Greg Harris explained the work involved.
“This year was just continuing to build on top of what we’d already done and what the teams in previous years have already established,” Harris said. “This team really kind of had a blueprint of what to do and
how to work. We had the right pieces and the people that have seen it and lived in and gone through it, and now wanted to take the next step.”
Lauren Service, the women’s soccer graduate assistant coach and a former player, expressed the same excitement and anticipation to get to where the team is now.
“I think everything has just kind of been a year of preparation and anticipation to get here,” Service said. “The team feels really good. We’re excited.”
In addition to their recent success, the team has also received a series of honorable nominations through the GAC. Harris has been awarded Coach of the Year by the Great American Conference, the latest in a series of such nominations. Further, the team has had four players on the All-GAC First Team: sophomore Kloey Fullerton, juniors Calle Citty and Maysa Willis and senior Whitney Thomas.
The team has also had a series of members on the GAC Academic Honor Roll: seniors Whitney Thomas, Reagan Thompson, Lacie Cabana and Kalyn Holeyfield; juniors Maysa Willis, Parker Barrow, Sami Berry and Kalyn Holeyfield; sophomores Campbell Cox,
Gabie Eddins, Eve Garrett, Norah Neely and Skylar Henley.
Harris expressed how proud he was of his team and how he instills the motivation to succeed in his team.
“We’re blessed to be athletes to glorify God and minister to people in whatever field that they choose,” Harris said. “They did all this and accomplished this and were able to walk across the stage now with the God-given opportunity to minister to others in whatever field they do.”
Once the final whistle of the championship game blew, the crowd erupted in cheers and the field was surrounded by fans, friends and families as they all celebrated the win.
Sophomore forward Nora Henderson reflected on the moment.
“It was great to see, especially the seniors; they’ve been working really hard and they’ve been really wanting this,” Henderson said. “We made it our goal at the beginning of the year, and so it was nice to accomplish that goal. This win just shows how we’re friends on the field and also outside the field.
Accomplishing things together means a lot.”


Harding Cares supports community after SNAP cuts
CARTER OWENS beat reporter
Following the federal government shutdown, thousands of people in Arkansas were affected by the loss of SNAP benefits, but Harding has partnered with the community to help those in need. Harding Cares is the effort created to provide food for those in the community. One of the leaders of the effort, Harding Assistant Provost Dr. Andrea Morris, explained the acute impact of the crisis and the response of the Harding community.
“There are 12,000 SNAP recipients in White County,” Morris said. “These are majority working families, the disabled and children. When the benefits stopped for all of them, it became a matter of urgent concern and required a strong, immediate and fullyengaged response. That is what Harding is a part of. Supporting our neighbors is not new for Harding. The relationships in place before this impact will continue to bear fruit after the urgency calms. While the shutdown has ended, we anticipate the impacts to families continuing through December. I am grateful for and humbled by how Harding is showing up for its neighbors.”
Morris said that many organizations and community members, with whom Harding Cares is partnering, help administer food to

and Executive Director Blake Cole leads the charge with Harding Cares to meet the needs of the community.
responded in a very good way and been very effective in helping Harding students that have a food or other need, the public with food needs and by supporting local food pantries and other nonprofits that are working to provide food to their clients,” Cole said.
Cole described the community’s response to the need.
“Searcy and White County are so richly blessed,” Cole said. “No matter the need or circumstance that arises, the people of this community come together to help their neighbors in need. This need has been no different. And finally, even though SNAP benefits have been restored and the government reopened, we plan to continue our food drive until the end of November.”
There are many ways students have helped and can continue to help. Junior Emma Gaskill, who has bought meals with others, described the way to serve.
people in White County to care for one another,
“Based on the very unique and unfortunate timing of the government shutdown, loss of SNAP benefits to families in need and existing food insecurity needs that exist on a daily basis, Harding and United Way have
“There are tons of ways to serve, no matter how much time or money you have, and it’s available on the SGA Instagram; there’s a link to the LinkTree,” Gaskill said. “I know also that students have all gotten emailed about it from Zack, so there are tons of ways to help regardless of how much time or money you have.”
The women’s soccer team celebrates a winning game 1-0 against Ouachita Baptist Nov. 16. The win secured the team a spot in the NCAA Division II Tournament for the first time since 2016.
Junior Holly Haslam drops off goods at a Harding Cares donation bin on campus. The Harding Cares initiative was developed to serve families in the community affected by the loss of SNAP benefits.
Photo provided by LAUREN SERVICE
Photo by BRILEY KEMPER
In this issue Mold in dorms, 2A Puzzles,
those in need. In partnership with the city of Searcy, the United Way of White County, 100 Families, ARcare and Sparrow’s Promise, Harding is one of the donation sites to collect identified foods and personal care items. United Way of White County exists to increase the organized capacity of
Warehouse 4 closes permanently
LORELAI CURTIS community editor
Warehouse 4, a coffee and bakery shop that served both the Harding community and Searcy residents, officially closed its doors on Nov. 7.
There was no official announcement before Warehouse 4 closed for good, which came as a shock to the student body and the people of Searcy.
“Honestly, I was really surprised,” said junior Sunny Ray. “I hadn’t seen or heard anything.”
The concern was not only that Warehouse 4 was closing, but also how abruptly the news was relayed to the employees and the community.
Sophomore Rachel Sims had been employed at Warehouse 4.
“I was told a week before Halloween, and we were informed that they were going to close on Nov. 17,” Sims said. “About two weeks after that, they said [the closing] was actually going to be Nov. 7.”
There was no notice or announcement made to the public about the closing, only speculation and hearsay.
Senior and ex-employee Jake Fitzpatrick
explained why the restaurant never made a public statement.
“He [the owner] thought that announcing the closing early would decrease sales,” Fitzpatrick said.
Students and patrons of Warehouse 4 have speculated on why it closed.
“My manager said that we weren’t making enough money,” Fitzpatrick said.
Unlike other food options on campus such as Starbucks, Warehouse 4 did not offer meal exchanges to Harding students.
Sims said that the restaurant had fought for meal exchanges to be incorporated.
“We apparently have asked before, and Harding said no,” Sims said. “Then we made a petition; I think like four pages worth of signatures, and they still said no.”
Sims said that Warehouse 4 was located inconveniently because it was near Starbucks and out of the way for students and Searcy residents.
The company did not explain the reason why the coffee shop closed. Aramark, the owner of Warehouse 4, and the Searcy location’s managers all declined to comment.


Mold in dorm rooms: Who is responsible for cleaning it?

Mold is not a prevalent problem on campus, but it has been an issue in some students’ rooms.
Junior Lena Givens and sophomore DJ Holder saw a lot of mold in their dorms in the past couple years and communicated with their Residence Life Coordinators about the issue. In both instances, the students were moved to another room.
Students are told to report any problems in their rooms – including mold – like Givens and Holder. Stephens Hall RLC Kara Chalenburg said she only has a couple of mold-related issues a year, but she does not know about problems in her residents’ rooms unless they file requests.
“See it, call it, we’ll come get it,” Physical Resources director Danny DeRamus said. “It’s important that we go check and make sure it’s not a problem.”
DeRamus said he had responded to maintenance requests about mold in rooms that were “spotless.” The Bison conducted
an unofficial test and took samples from 11 residence halls. Some were taken the day of a health and safety check, but mold appeared to be present in all samples despite the cleanliness of the room.
So what is expected of students and what is expected of the University when it comes to treating mold in dorm rooms?
The Residence Life handbook said students are expected to keep their “assigned room reasonably clean at all times.”
The definition of what is ‘reasonable’ may vary in different dormitories. Cathcart RA and junior Joanna Huff said there is not an explicit checklist for health and safety; her expectations are based on past dorm meetings and expectations from previous RAs.
Some RLCs implemented practices to prevent mold. Chalenburg checked rooms between every summer session and before students arrived in August. Harbin RA and senior Isaiah Phelps said residents are expected to clean around the AC units before moving out because of a mold incident a few years ago.
Although RLCs are proactive, DeRamus said Physical Resources does not proactively test for mold; employees only conduct tests if maintenance requests require them. The most prevalent types of mold DeRamus sees are aspergillus and penicillium – two of the most common types of fungus in indoor environments, according to the National Health Institute.
The Bison’s samples were not tested by a lab, but were compared with pictures and descriptions in the test’s identifying guide. Pictures of each sample were also sent to the test’s company for analysis. The most common molds found in the residence hall samples were moderately hazardous molds like penicillium and aspergillus. One sample appeared to contain stachybotrys – a toxic fungus commonly known as “black mold.”
Identifying the specific mold is not crucial because mold is not an isolated problem. The Centers for Disease Control and Prevention said the presence of any mold means there is a moisture problem, like leaking pipes, and both need to be fixed.
“Once we can fix the source, the mold is no longer a problem,” Chalenburg said.
The consensus among Harding employees was that students are not responsible for treating mold.
Chalenburg said she tells residents to file a maintenance request if they find mold. In addition to keeping rooms clean for health and safety, Chalenburg said students can help prevent mold issues by keeping their bathroom doors open when possible to prevent moisture condensation.
“I don’t think that there needs to be any undue responsibility on the student for cleaning beyond normal cleaning products that you would use in your own bathrooms,” Dean of Student Life Zach Neal said. “The responsibility of the student is to make sure that they’re properly reporting. They would talk to the Residence Life Coordinator, make sure they follow the procedures of that residence hall.”
Department of Music hosts Holiday Spectacular concert
Yesterday, Harding’s Department of Music hosted its annual Holiday Spectacular concert featuring the Chamber Singers and Jazz Band. The concert took place in Cone Chapel with the dazzling Christmas lights of Harding’s front lawn in the background.
Kyle Pullen, director of the Chamber Singers, described the appeal of the event and location.
“It’s more intimate,” Pullen said. “The audience is just right there with the ensemble.”
This semester, the Chamber Singers are a select group of 17 highly qualified members, all of whom are also members of the University Chorus. They sing a variety of genres from a cappella to Renaissance motets. For this year’s holiday spectacular, the group performed five arrangements of Christmas carols, ranging from classical to more popular styles.
“My favorite is a beautiful arrangement of ‘In Dulci Jubilo’ by Matthew Culloton,” Pullen said. “It has an interesting flow to it, very beautiful.”
Michael Claxton served as MC for the evening and a saxophone quartet played as an interlude between the Chamber Singers and Jazz Band. In the past, the concert has featured smaller groups such as string and percussion ensembles.
The quartet consisted of Andrew Cook’s private students: seniors Matt Wells, AJ Lopez and Dominick Perez, and alum Jackson Price. Cook is the director of the Jazz Band.

“I would play with them because I’m a saxophonist, but I’ve got enough other things to do for the concert,” Cook said.
Under his direction, the Jazz Band played traditional Christmas tunes like “Oh Christmas Tree,” “We Wish You a Merry Christmas” and “The Holly and the Ivy.”
Cook reflected on the significance of the concert and the holiday season.
“Ever since I’ve been here, we’ve done some kind of a Christmas program,” Cook said. “It’s a really nice way, because we are all just completely swamped at the end of the semester, but how can you be stressed
when you’re listening to Christmas music? It’s like a reward at the end of the semester each year and just a nice reminder to embrace the holiday season and enjoy it and slow down.”
KENZIE JAMES news editor
Mold grows above the bathroom vent in a Shores Hall apartment. The fungus is one of The Bison’s samples.
Photos by KENZIE JAMES
Photos by ELENA KALLENBACH
Photo provided by JEFF MONTGOMERY
MICHAEL WRYE beat reporter
The Warehouse 4 building is on Dr. Jimmy Carr Drive and Woodruff Avenue. The coffee shop and bakery permanently closed on Nov. 7.
The Harding University Jazz Band performs on the Reynolds Recital Hall stage. The Jazz Band performed a joint holiday concert with the Chamber Singers on Nov. 20.
Mold from residence halls grow in petri dishes. The samples are part of The Bison’s unofficial test.
TOP: Grad, Pryor, Shores indoor, Shores exterior. BOTTOM: Pattie Cobb, Stephens.
Photos by KENZIE JAMES

“When the agreement of men is taken away, virtue has no existence at all; for what are the interests of our country, but the inconveniences of another state or nation? “
-Lactantius, The Divine Institutes, Book VI, Chapter VII.
In this passage of “The Divine Institutes,” a theological work from the early fourth century, Lactantius provides perhaps the earliest and most overt condemnation of nationalism that we have from the early church. It should be no surprise that Lactantius takes such a negative view towards the empire, as the Diocletianic Persecution began the same year that he began writing “The Divine Institutes.” Throughout Church history, desperate clingings to nationalistic sentiment have generally led to persecution. Fourth-century persecutions under Athanaric, a king in the Tervingian confederation of Goths, echo those of the first century under Rome. In both cases, social and religious orthodoxy were challenged by the emergence of a Christian lower class. Whether memorialized in the martyrologies of Stephen, Polycarp or Sabbas the Goth, the results of nationalism are clear.
We live in an interesting, though not necessarily unique, period of Christian history. Unlike our counterparts in the ancient world, Christians in America do not experience any form of overwhelming persecution. The American church lives in a sort of marital partnership with the American state, wed by large portions of the political right and left. As a result of this partnership, a new “Christian” nationalism has emerged. This nationalism, similar to ancient forms, is a kind of uninformed loyalty to a social and religious orthodoxy, wrapped in a blanket of American values and virtues. It is the most pressing issue for the American Church to address within itself.
Not wishing to beat around the bush, it is my belief that “Christian” nationalism has been especially visible in the wake of Charlie Kirk’s assassination. I haven’t agreed with him once since I was in the seventh grade. At the same time, I can agree that he did not

The Sunday sermon recently was about loving thy neighbor, the homeless and the addict, the theoretical vagrant. The pastor said that I ought to reach out to them and help them – because, he said, they are just like us actually, and if I am afraid of them, what does that say about me?
He did not acknowledge, as he should have, that some of them are dangerous – and still just like me – which is infinitely more frightening. It’s not always the quiet woman with the baby standing in the sun, who only needs a chance. It’s also the tall man without teeth who smells unwashed and follows you down the street. That’s a picture much harder to see with rose-colored glasses or to assist with outstretched hands. And yet: “Whatever you have done for the least of these, ye have done for me.”
Last spring, the Wall Street Journal followed up on an earlier story about an award-winning lawyer who’d begun a fancy job in Los Angeles in 2022, disappeared, and months later was found to be living on the streets, alone, panhandling, unkempt, in the depths of schizophrenic psychosis. His family tried and failed to bring him home; when found, he didn’t want to leave. A man who’d had it all – money, renown, influence, a mother and sister who loved him and searched for him – fell through the nets of society and landed on the sidewalk, hard.
One can imagine the readers of the Journal, most of them wealthy, well-dressed, with several cars and a 401(k), reading the story and looking up (out the penthouse window to the skyline) in abject horror and with more than a little bit of fear. I don’t count myself among the New York elite, and I don’t have a 401(k), but I admit I read the story with the same horror and fear.
The Great American Heresy
deserve to die and I went as far as personally rebuking those who celebrated it. Even in the immediate aftermath of his passing, I publicly balanced these two perspectives, because I knew that they were not mutually exclusive. Yet, from the political pulpit, a different picture has emerged. Attendants of Kirk’s memorial saw, and applauded, a man bearing his cross with wheels for added ease – as Jesus intended, I’m sure – against an altar of American exceptionalism. Attendants heard from Jack Posobiec that Kirk’s death was not a murder, but a “sacrifice” that will eventually lead to the salvation of the West. In the wake of his death, Posobiec urged these attendants to put on the full armor of God in preparation for a battle, an allusion to Ephesians 6, but without the nuance of such metaphorical terms like breastplate “of righteousness” or sword “of the Spirit.” Several media outlets reported on the clear presence of “Christian” nationalism following the memorial in far greater detail than I have liberty to go into in this opinion piece, so I would recommend referring to those outlets. In any case, it is my contention that the memorial sought to blend that which is American with that which is Christian.
The American church has been gripped by Stockholm syndrome. We excuse patriotism or nationalism because, after all, we live here. We made Christianity easy because, after all, why can’t a cross have wheels? “Christian” nationalism is a hollow imitation of Christianity. Lactantius understood this because he knew that the state cannot imitate Christ. When proponents of Christianity attempt to balance its values with that of a state, which by necessity will use coercive power as a means to guarantee its survival and maintenance, they cheapen Christ’s sacrifice. Similarly, when proponents of Christianity attempt to balance its values with those of a people group, they promote tribalism that ultimately denies the result of Christ’s redemptive work.
Church. Jesus’s words in Matthew 6:24 echo this simple truth: “No one can serve two masters. Either you will hate the one and love the other, or you will be devoted to the one and despise the other. You cannot serve both God and money.” If the Church serves Christ, how then can it serve the state also? Again, in Luke 14:26, Jesus proclaims that “If anyone comes to me and does not hate his own father and mother and wife and children and brothers and sisters, yes, and even his own life, he cannot be my disciple.” I suggest that many patriots within the Church would have difficulty balancing these verses with their own nationalism.
It is my sincerest desire that American Christians recognize that the American government does not represent Christian ideals. The United States continues to fund wars, enforce genocides and carry out justice unevenly. In this, it follows a sacred tradition of fallen humanity. But Christians must not be confused. This is not what a “Christian” government looks like. The “Great American Heresy” teaches that in spite of its sins, America is somehow inexplicably favored by God above all other nations. It is an American blend of the spiritual and the temporal, bound in a neat red, white and blue bow.

The Church cannot be reconciled to the state, nor can the state be reconciled to the
Fear and Fairness
If a man like that is vulnerable, what am I?
I’m not talking about welfare systems or happily-discussed, never-implemented “safety nets.” I’m talking about how easily we ourselves can become outcasts, hungry, naked – and how we fear it happening. We’re all one disaster away from it, and we can feel it. And we know how we would be looked at, there on the street in the sun, ignored; because we do the same to the people there now.
It’s important to remember that the homeless and addicted can be dangerous; yes, but they are also human. That sounds sanctimonious, but really that’s all I can say. I don’t have any solutions. I think to myself: Shouldn’t I give joyously what I have (a five dollar bill, the only cash I carry)? Will I enable them? Harm them? Is it better if I ignore them (and their problems and their infinite soul and likeness of God and their heart and…)? But everyone says not to give them money, just to drop off
a can or two at the pantry down the street. It’s either that or invite them to dinner at your apartment, apparently.
C. S. Lewis once wrote something along the lines of “Empires rise and fall, great nations come and go, but the man who poured your coffee this morning is immortal, because his soul is immortal.” The same is true for the man who asked you to buy him coffee outside of 7-Eleven.
The least I could do, I guess, is to look someone in the eye when I’m stopped at the light, instead of pretending they don’t exist. Acknowledging the presence of someone, even if it’s uncomfortable, is doing much more: it is remembering their (and your own) humanity, it is practicing warmness of heart, even if you have nothing to give but a silent prayer. staff
Randi

Time of writing: 4:33 a.m.
So… big news week, eh?
Sorry, I don’t mean to be a drag. I don’t mind if y’all don’t read the news. If I keep all the stories to myself, technically I do all the reporting, which means more money into my bank account. Anyways, even if you avoid the news, you can’t deny some big stuff happened. The Epstein files dropped, Uncle Sam 86’d the penny, we know who plays Malfoy in the new Harry Potter TV show; we even lost an admissions counselor.
We at the Bison performed a lil’ study on some living areas around campus, and, breaking news, we found mold. I know absolutely nobody is susprised by that. I myself know exactly where to look to find my room mold, and if you give me a shot I bet I could find yours.

All this drama really got my writing spirit up-and-going, so I wrote a couple of headlines for a future gag about mold. Read through those and tell me which one you like the most.
“Oops! Harding University accidentally puts mold on the walls instead of wallpaper. Derr!” No… that’s too comedic; why would anyone confuse the two, mold and wallpaper? It doesn’t make sense. How about this one:
“Breaking news: Harding hid dozens of murderers across campus inside student housing.” That phrasing is more factual, sure, but that implies Harding put the mold in our housing on purpose, and even I wouldn’t go that far. Try this one on for size:
“Students develop genius way to clear out unwanted roommates while losing 30 pounds— scientists hate them!” No body shaming? Check! No defamation? Double check! Doesn’t endorse consuming mold for its alleged and entirely counterfeit health benefits? Triple - GAH. Jeepers creepers, how’d that sneak in there? No. I absolutely cannot put a joke about eating putrid black mold masses in The Bison. What if someone actually did it? I don’t want to cover those medical bills. I need something more newsy, more striking…
“Stachybotrys Chartarum, the mold The Bison suspects is infiltrating student housing, may cause a variety of respiratory, dermatological, eye and constitutional symptoms.” Gr! Gah! No! That’s not even a joke! That’s just what happens when you undergo heavy and prolonged exposure to black mold. Clearly, the facts aren’t enough to sway the reader. Maybe I need a humorous take…
“Johnson and Johnson’s sugar-free mold spores are the trendy up-and-coming plant that your bathroom needs! Just use our custom plastic catalyst to spread a small amount of spore on your walls and turn on a hot shower; the rest is up to the mold! Before you know it, your walls will be covered with fragrant, steaming, putrid filth. Turn your sitting room into the talk of the town. But wait, there’s more! Order today to receive a free petri dish chock full of Aspergillus bacteria, the pork chop and apples to our Stachybotrys mold spores. You will not be disappointed by the vibrant colors and smells emitted by our bacteria, and neither will your neighbors. Call now before it’s too late!” Sounds… cringy. Few people watch TV, and fewer like ads. Too niche of an audience for my article.

Melanie
Edgar Cardiel
That’s all I have. If you haven’t opened your windows in a while... maybe do that. Give your immune system a fighting chance. Get those responses in by Friday… but mind you send it during my waking hours. If I’m up… too long… I get so… zzz
Natalia
Nona
Copy editor
Clara Kernodle
Opinions editor Andrew Reneau
Guest writer
Max DeLoach
CLARA KERNODLE is a copy editor for The Bison.
MAX DELOACH is a guest writer for The Bison.

Samples of gold
Editor-in-chief Randi Tubbs
All you need is love
This past weekend, I traveled to Dallas with Dr. Monte Cox’s Living World Religions class and visited seven different religious buildings representing Hinduism, Buddhism, Islam, Sikhism, Judaism and Baha’i. At each stop, a practicing member of that religion explained their core beliefs, answered our questions and sometimes even invited us to observe their worship. Hearing people speak about the most sacred parts of their lives, I realized something surprisingly simple (as original as it may sound): We are all far more alike than we think. Here is my incomplete list of everything I saw inspiration through Samples of gold. At the Hindu temple, I saw Samples of deep reverence for the divine within every person. Practicing Hindus believe there is a drop of Brahman (the infinite source of souls) inside each of us, meaning the divine is not distant but present in every human being. Anand Pandit, the Hindu speaker, explained that their greeting, “Namaste,” means “I bow to you,” acknowledging the divine in the other person. That sentiment struck me. Whether or not they would phrase it this way, it reminded me that God made each of us and dwells in each of us, making each of us worthy and of value. It felt like such a profound meaning for such a simple greeting, one I wish Christians more openly embraced.


At the Islamic mosque, I saw Samples of deep devotion grounded in equality. One of the speakers emphasized that in worship, everyone stands side by side—whether wealthy or homeless, educated or uneducated, high status or low. Muslims pray five times a day, no matter where they are. They fast for an entire month from dawn to sunset. They take a sacred pilgrimage to Mecca, joining thousands or even millions of others. Their spiritual discipline made me wonder how our Christian devotion might change if we approached God with that same consistency and intentionality.

At the Buddhist temple, I saw Samples of commitment to transforming suffering into compassion. Many Buddhists follow the Eightfold Path, a way of living that encourages right speech, right action, right effort, and more. Listening to Ken Goldberg explain what these principles meant to him honestly felt like sitting through a Christian sermon. So many parts of Buddhist ethics—compassion, accountability, mindfulness—mirror what Christians strive for too. Learning about a Buddhist lifestyle reminded me that people really do care about becoming gentler, wiser versions of themselves. I interpret that as the Holy Spirit working through them.
At the Sikh gurdwara, I saw Samples of radical hospitality practiced with joy. We participated in the langar, a free community kitchen that exists in every Sikh house of worship. Anyone, regardless of background, belief, or social status, is welcome to share a meal. They make the food vegetarian so that all can eat together in equality. The Sikhs I met embodied the servant-heartedness that Christians often talk about but struggle to consistently live out. They made me want to be more open, more giving and more intentional in serving others.
At a different Buddhist center, one belonging to the Nichiren sect, I saw Samples of the power of prayer expressed through chanting. They practice Nammyoho-renge-kyo, a form of vocal prayer meant to bring clarity, courage and compassion. In small groups we were able to ask anything, and many of our questions centered on chanting. The members explained their experiences in ways that sounded incredibly familiar— praying for guidance, for others’ wellbeing, for peace during hardships. Their vulnerability mirrored the same states Christians enter when we pray. And honestly, I find it hard to believe that these people are crying out for goodness and guidance and that God somehow doesn’t hear them.
After visiting all these places, I’m convinced that beneath our different rituals and languages, we’re all reaching toward the same things: love, peace, purpose, and something greater than ourselves, sentiments that Maggie Samples never failed to actively explore and implement. It was an honor to see yet even more Samples of her this weekend.
Even if you aren’t online, many of you are probably aware that it is currently “Dancing with the Stars” season. Not only is there an online community for this show, but it has also started to take over Harding. I never watched this show until I came to college, but I am thankful for the people who convinced me to start it. As well as having an entertainment factor, it has the ability to bring people together. Like a number of people on campus, I look forward to 7 p.m. on Tuesday nights where I can watch DWTS with my roommates and talk about the dances and who we think is going home every week. Even more, I can go to the Stu the next day and see what everyone’s reaction to the latest elimination was.This type of camaraderie has been slowly starting to die with the rise of streaming. Nowadays, a TV show will release all of its episodes in one day and everyone will watch it by themselves whenever they want. While this is convenient, it loses the high spirits of a live airing. Having to wait for a new episode every week helps to build the anticipation, which is lost in hours-long binging sessions.
This isn’t the only TV show that has become a weekly event in our dorm. Since freshman year, I have tuned in at 10:30 p.m. every Saturday night to watch Saturday Night Live. Watching this show helps me connect not only with my friends, but with the culture as a whole.
As Amelia Slater puts it, “SNL is a big landmark of pop culture of the times, you know? It really represents what’s going on politically, socially and what’s funny these days.”
While we may not always understand the political sketches, they present it in a way that satirizes what may usually be viewed as a politically gray landscape and
There’s Nothing Like Live TV
helps us to laugh it out. The great thing about SNL and other shows like it is that it reacts to world events at the same time we do. Other shows may be watched in hours-long spurts on a weekend or may be put off to watch during winter break, but shows like these need to be watched live, and that’s what brings a different energy to the watching environment. While I look forward to the freedom I will be gaining after graduation, I am going to miss the weekly TV nights with my friends. As a senior, I urge you to find something to watch live with your friends this semester. Maybe it’s a sports team you all want to follow together, the new
season of “Survivor,” or even follow suit of me and my dorm and watch SNL and “Dancing with the Stars.” You don’t have to be a dancer or an athlete, and the show doesn’t even have to be good! Sometimes a horrible plotline or a cringy character is enough to carry the conversation for the rest of the night or create an inside joke you’ll come back to again and again. Whatever you decide, don’t take that hour for granted. Assignments come and go, but reality TV is forever.

Every Four Weeks
Last week I was driving to campus and heard an ad on the radio for Rock City Outfitters. I had to laugh when I heard them promoting their “T-shirt-of-the-Month Club,”where subscribers can send in $19.95 every 30 days and receive a different t-shirt in the mail. Since I buy a new one maybe every five years, I am clearly not the target audience.
But the ad evoked memories.
There’s a climactic scene in “National Lampoon’s Christmas Vacation” where Clark Griswold is anxiously awaiting his annual bonus. It’s been delayed for weeks, and he wants to announce to the family that he’s putting in a swimming pool. When the delivery guy finally shows up on Christmas Eve, Clark trembles as he opens the envelope, his mind imagining the amount on the check.
Then he reads the message: “It’s a one-year membership to the Jelly-of-the-Month Club.”
After his cousin Eddie’s classic line—“That’s the gift that keeps on giving the whole year”—Clark goes ballistic. He tears into his Scrooge-like boss with a colorful diatribe, hurling every adjective he can think of. Several of which are hardly fit for a wholesome newspaper such as ours.
Incidentally, when I went to the Arkansas Comic-Con earlier this semester, I heard Randy Quaid (who played Eddie) talk about the filming of this scene. He pointed out that the rant was so long that Chevy Chase was afraid he couldn’t remember it all. After several takes, Quaid came up with the idea of writing bits of the speech on cue cards that the rest of the cast could wear around their necks. As they all stood with their backs to the camera, Chase went on his tirade, cleverly filmed so the audience wouldn’t know he was reading it. This makes me feel better about writing nine lines on my hand that time I was in a play.
A variation on the “Jelly-of-the-Month Club” also became a running joke on “Everybody Loves Raymond.” Ray tries to give a gift to his parents

but picks a real lemon when he signs them up for the “Fruit-of-the-Month Club.” Frank and Marie do not handle it well, overwhelmed by the nonstop produce being delivered to the house. “We can’t even think with all this fruit around,” Marie yells.
Graphic by GRACE BROWN

While the subscription model of marketing goes back several hundred years, the modern version started with the “Book-of-the-Month” Club in 1926. Nearly a century ago, Harry Scherman came up with the sales pitch that would let subscribers build their libraries with twelve new books per year, often at the publisher’s choice. I was part of such a club when I was six. Every month, I would get a new volume in the “Sweet Pickles” series. These were charming stories about 26 animals, each of whom would
get into a mess—a “pickle”—because of some characteristic trait. Naturally, there’s an animal for every letter of the alphabet: “Vain Vulture” is obsessed with his appearance, “Questioning Quail” can’t make up her mind, and “Yakety Yak” won’t stop talking. Kids who could hang on through the whole two-year subscription would receive a poster, a decal set, and a plastic bookcase. I have to confess that I did not make it. It’s not that I didn’t like the books. It’s just that the series came out about the same time as “Star Wars,” and my mind suddenly was far off into another galaxy.
The same thing happened with my “Story of America” cards. I think a relative signed me up, and every month a set of cards arrived in the mailbox. Each described an event from history, and the series came with a plastic tray and topic dividers so you could file your cards by time period. As a college professor, it’s embarrassing to confess that my youthful efforts at reading fiction and studying history were eclipsed by R2-D2, but that, I am afraid, is what happened. We now sign up for digital subscriptions so often that I’ve seen ads for companies that will help you cancel the ones you forgot you had. You have to love capitalism: “Send us money, and we’ll delete your impulse buys.” Some purchases are so bad that you have to hire lawyers to extricate yourself, as anyone who owns a time-share condo well knows.
There’s a club for everything, from the Slime Box Club to Skulls Unlimited to the Gnome of the Month. You can even get beef jerky delivered regularly to your mailbox. Surprise a loved one this Christmas with the “gift that keeps on giving,” and they’ll remember you fondly every four weeks.
Narrative columnist Michael Claxton
RANDI TUBBS is editor-in-chief for The Bison. She can be contacted
Comic by GRACE BROWN
Guest writer Lindsey Triplett
LINDSEY TRIPLETT is a guest writer for The Bison.
Lady Bisons stun No. 3 Texas Woman’s
TUCKER ALLEN guest writer
The No. 25 Harding Lady Bisons women’s basketball team delivered a statement win, beating the third-ranked team in the nation, Texas Woman’s University, 75-59, at the Texas Woman’s Tip-off Classic on Nov. 8. The victory marks the first time since 2011 that Harding has defeated a top-three nationally ranked opponent, moving the Lady Bisons’ early-season record to 2-0 after also defeating No. 23 Tampa the previous day. Junior guard Josie Williams, who tallied 13 points, stressed the team’s consistent focus leading into the matchup.
“We went into this game just like we do any other game. We were focused on us and the things we can control,” Williams said. Harding controlled the game from the start, leading for over 38 minutes of play and building a game-high 22-point advantage in the third quarter. Texas Woman’s struggled to mount a comeback, scoring only nine points in the final quarter.
The Lady Bisons’ success was rooted in a decisive 46-27 rebounding advantage, a margin fueled by 16 offensive boards that led to 18 second-chance points. Junior guard Maddi Holt, who scored 13 points, emphasized the team’s focus on controlling the glass.
“Before every game, Coach Kirby reiterates rebounding, especially offensive rebounds,” Holt said. “Offensive rebounds are very detrimental to opposing teams’ energy, and if we can handle that and beat them in the rebounding battle, everything gets easier.”
Freshman guard Kori Sanders added that the team’s approach was key to the upset.
“We really weren’t thinking about their ranking as much as we were locked in on executing and winning each possession,” Sanders said. “I think what caught them off guard was our competitiveness and the way we played with so much energy and toughness on the boards.” Harding also found

a rhythm from beyond the arc, sinking 10 three-pointers and shooting 46 percent overall from the field, while holding the Pioneers to just 38 percent. Freshman center Kennedy Stout led the charge with her first collegiate double-double, finishing with a team-high 17 points and 12 rebounds.
For Holt, the back-to-back wins against ranked opponents prove that the Harding program remains elite despite graduating
three key players last year and bringing in several newcomers.
“I think it just says we are who we’ve always been,” Holt said. “We graduated three key players last year, and many doubted us because we brought in six freshmen and one transfer, but those two wins showed that we’re still one of the top programs.” Junior Guard Kinley Hammitt shared her pride in the team’s cohesion.
“I think my first thought was that I was just so proud of this team because we have worked so hard this entire year and have built those strong relationships with each other on and off the court, so to see that all come together in the game was amazing,” Hammitt said. “I think this win was super encouraging for us and a great way to start the season.”
Women’s volleyball comes back from 0-2 hole to beat OBU
NONA
NIELSEN beat reporter
On Tuesday, Nov. 4, the Harding women’s volleyball team played and won against undefeated rival Ouachita Baptist. Two sets in, Harding was down 0-2, but by the end, the women came back in a “reverse sweep” to win 3-2.
Women’s head volleyball coach Meredith Fear said that there was an anticipation to play Ouachita.
“We knew Ouachita would be a good match,” Fear said. “They are a seasoned team with a lot of four-year starters on their squad. We also knew we had improved a lot since our first round of conference. Even when we went down 2-0, we knew we were still capable of getting the win.”
Fear said that it was exciting to see the women’s confidence in themselves grow as the game continued on. Fear also said that there was a big energy shift at the timeout in the third set when they were down. Junior Olivia Wiedower, who plays as a setter for the team, agreed, saying that there was a shift in the team’s mindset.
“That game was so intense, and it was point for point each match,” Wiedower said. “But I think at the end we wanted it more. We also wanted to keep our perfect win streak at home. What led that comeback was, we recognized that nobody is just going to give us that win, we have to fight for it too. We didn’t want to go out easily.”
Senior middle blocker Jacey Lambert said that a lot of effort came together to make the win for this game happen. She said that the game was a culmination of all of the hard work that had already happened behind the scenes.
“Knowing that you’re giving your all for a group of girls that have your back and trust you on the court is an amazing feeling,” Lambert said. “When all of it is put together, we have trust, hard work and energy, and you can really see it coming together, especially during this game.”
With the regular season over and the Bisons finishing with a 23-4 record, they will look to keep going strong in the GAC tournament. The Bisons are the #2 team in the conference, looking to strive for success the rest of the season. Lambert said that the team’s work was not finished.

Malykhin named National Scholar Field Athlete of theYear
This season, 11 athletes received AllAcademic Athlete honors from the U.S. Track and Field and Cross Country Coaches Association. Senior Vlad Malykhin was further recognized by being named the 2025 NCAA Division II Men’s Indoor Track and Field National Scholar Field Athlete of the Year. Malykhin has amassed international pole vaulting awards, both for Harding as a student athlete and for Ukraine while representing his home country. But it hasn’t all been easy for the athlete from Shostka, Ukraine. For several parts of Malykhin’s vaulting career, he borrowed competitors’ poles. On the way to a competition in Colombia, Malykhin’s poles were lost in transit. At that competition, he asked a team from Germany if he could borrow one of their poles.
“So I asked this German guy, and he says, ‘Let me ask my coach,’” Malykhin said. “His coach said, ‘OK, you can.’ I qualify, he doesn’t.” After the competition in Columbia, Malykhin’s poles outright vanished, and he resorted to asking competitors to borrow their poles. This worked when he faced someone who used his exact pole measurements, but sometimes this meant he was forced to play with foreign gear.
Malykhin had repeatedly asked his Ukrainian team to replace his poles, but they refused. He tried asking if the shipping company would help, but they only offered him $200 of baggage replacement, which was only a fourth of the $800 that replacing the poles would cost him.
The pole story came to an end after Malykhin’s friend, a fellow sports athlete from his college, told him about Harding. A few days after Malykhin’s friend told him about Harding, he received a call from the track coach.
“After a couple days, the main coach from the track team called,” Malykhin said. “He called me, we talked with him a lot. My English was terrible, I couldn’t speak—I felt he was a really good man.”
The result of those conversations is Malykhin now playing competitively for both his home team in Ukraine and for Harding University. Since coming here, the pole vaulting team has expanded from around five to more than 25 members.
Senior Katie Shanks appreciates watching pole vaulting, and remembers wanting to try it at her junior high.
“A lot of people wanted to pole vault,” Shanks said. “I remember my coach telling

us, “I’m going to be honest, if you are not really fast, you are not going to be able to do it. So I gave up, but I remember watching my friends do it, and I was impressed because it takes a lot of strength.”
Others like watching the sport, but don’t understand why people play it professionally.
“I don’t really understand the purpose of it, I guess,” senior Evelyn
understand the concept
but to me it just seems like a
go
a professional
Photo provided by Reese Mallett
Filleman said. “I
(you
really high),
circus trick in
sport font.”
Photo provided by JHarrison Photography
Freshman Laykin Moore looks to drive into the lane during the Lady Bisons’ preseason victory over Texas Woman’s University Nov. 8. The defending GAC champions are looking to start their regular season off in a strong way.
Sophomore Maddie Burrough tracks the volleyball to keep the play alive during Harding’s 3-2 win over Ouachita Baptist Nov. 4.
ANDREW RENEAU opinions editor
Photo provided by Scott Goode
Senior Vlad Malykhin celebrates after a pole vaulting attempt during a track meet during the 2025 season.
Local ministry steps up amid shutdown
Thursday, Nov. 13, ended the 43-day government shutdown, the longest shutdown in United States history. The shutdown was a hard time for many people and prompted others to help out where they could. His House, a benevolence ministry out of College Church of Christ in Searcy, was no exception.
His House regularly distributes food on Mondays and Thursdays from 12:30–2:30 p.m. In light of the shutdown, they opened a temporary food distribution for White County residents with EBT/SNAP benefits on Wednesdays from 5:30- 7:30 p.m. This provided an extra food outlet to those who work and cannot make the usual food drive time.
Pat Howe, one of two deacons over His House for College Church of Christ, spoke on the proven need of the food distribution.
“We were unsure how many people would show up,” Howe said. “The answer came the next Wednesday night when we ran out of food after 125 families arrived and about 30 families could not be given food.”
His House has been serving the community for years. It strives to be a place of hospitality, hope and connection. Gale Hanna, one of the leaders of the ministry, expressed how the purpose of His House goes further than food distribution.
“The main purpose of His House is to be a place of hospitality and hope,” Hanna said. “It’s where anyone can come and find tangible help and human

connection. Yes, they distribute food, but what they’re really offering is relationship, prayer and a reminder that no one is invisible in this town.”
Andrew Baker serves as a connection between 100 Families and Harding University to His House. He urged working together for the greater good of the community and offered encouragement to anyone wanting to get involved.
“Don’t overthink it—just show up,” Baker said. “You don’t have to have a special skill set to make a difference. Pack bags, greet families, carry groceries, play with a child while mom picks up food—every bit of it matters. You’ll leave feeling like you got more than you gave.”
Services like this encourage outreach and deepen our sense of calling. Showing compassion for others is both a strength and a challenge, and it is one that His House has embraced in a time of need.
“His House is a reminder that compassion doesn’t belong to one organization; it’s a shared effort,” Baker said. “When a grandmother walks across town pushing a stroller, or when a student stops studying long enough to pack a food bag, both are acting out the same truth: We belong to each other.”
City starts park project with Arbor Day planting

Four ginkgo trees were planted on Nov. 14 along Race Avenue, signaling the start of developing Fern Cowen Rodgers Park and serving as this year’s Arbor Day celebration.
The city of Searcy is a member of Tree City USA. As a requirement, the city must plant a tree each year and hold an Arbor Day event.
“We do it every year; we pick a different site, and this year we’re starting to design and develop Fern Cowen Rodgers Park,” Searcy Planning and Development director Richard Stafford said. “We have an early concept design that has trees along Race Ave.”
The Searcy Tree Board chose to plant ginkgo trees to bring the atmosphere of downtown to the park.
“They [the ginkgo trees] go down Spring Street and the First Security Bank building, all along that perimeter edge,” Stafford said. “So we’re trying to tie this into some of the ginkgo trees that are already downtown.”
The Rodgers family donated the park to the city in honor of their mother, Fern. The park is located beside the Black House, also known as the Searcy Art Gallery.
“We are so thankful that [Dr. Rodgers, the son of Fern] wanted that to be a memorial park for his mother,” Searcy Art Gallery director Debbie Higgins said. “And to have it be such a peaceful, resonating place, a green space that people can come.”
Fern Cowen Rodgers Park will be unique to Searcy, occupying the property where the Rodgers family home once stood.
Mike Parson, the department head of Parks and Recreation, explained the location for the planting. “This year we were trying to think of someplace [the tree planting] could really be impactful,” Parsons said.
The park is designed to give the community a quiet green space to enjoy the surrounding landscape.
“The Rodgers family wanted it to be this serene place where you could come and sit and enjoy the outside,” Stafford said. “The design is based on a Savannah-style square garden, so that’ll be unique to Searcy.”
The plans for the park are inspired by the gardens and city squares of Savannah, Georgia, and Charleston, South Carolina.
“There’s going to be a fountain in the middle and then some flower beds and gardens around,” Stafford said.
The fountain and gardens will bring many to the park, but the trees will make an even deeper impact.
“The trees are going to be a big deal,” Higgins said. “They’re going to be ornamental trees because they’re going to be beautiful in the spring and fall.”
The park’s location between two historic homes heavily influences its design and the atmosphere planners hope it will create. The Black House sits to the left, and the Watkins House, a red brick Italianate, stands to the right.
“I think it does nothing but enhance our homes on this street and on the way to Harding,” Higgins said. “We could not be more thrilled with it.”
Crispy Cones sweetens Searcy with local flavor
Crispy Cones, located on Beebe Capps, opened in early May 2025, bringing new sweet treats to the Searcy community.
Harding alumnus Dylan Johnston, is the franchise owner of the Searcy location.
“We made it known from the get-go that this is not a big franchise brand,” Johnston said. “This is a local business.”
As a Harding graduate, Johnston said he wanted to give back to students by offering social club discounts. Crispy Cones currently provides two club-related deals for new beaux and queens and for club meetings.
“The person who got beauxed or queened gets a free Crispy Cone and the whole club gets 15% off,” Johnston said. “The other idea was club-meeting night. Instead of going to Sonic, everyone could come to Crispy Cones.”
Customers say the environment is part of the appeal. Sophomore Addi Griner described the shop’s atmosphere as upbeat and welcoming.
“It was pretty lively,” Griner said. “There were a lot of people, but the line was not crazy long; they were getting through people fast. Music playing… it was really fun.”
Even though Crispy Cones is new to Searcy, the shop has already made a noticeable impression on both its customers and employees.

Junior Annie Sparkman is an employee at Crispy Cones. “I like the small business aspect of it, because I feel like normally small businesses are better to work for,” Sparkman said. Griner was excited about the new discounts.“Everyone loves a sweet treat, and especially on nights when people are being queened and beauxed, they love to go somewhere,” Griner said. “And this would provide another option than just Sonic.”
Crispy Cones has brought the community together in more ways than many expected. As a small business, it has also connected with other local owners who are eager to support one another.
“The local businesses really team up together,” Johnston said. “We’ve done collaborations with Knight Fire Barbecue and other local businesses in town, saying, ‘If you go buy a meal over there, you get a discount over here.’”
Crispy Cones is also going to give discounts to Harding students and faculty anytime they come in.
“We now do a Harding discount, so just show your Harding ID,” Johnston said “We’ll give you a dollar off anything [when] you come in.”
With new promotions, community partnerships and a growing student following, Crispy Cones hopes to continue strengthen its place in Searcy.
LORELAI CURTIS community editor
LORELAI CURTIS community editor
SIDENY DAVIES beat reporter
One of the ginkgo trees at Fern Cowen Rodgers located on Race Avenue. The trees were planted as part of this year’s Arbor Day celebration.
Located on Beebe Capps, the shop displays the Crispy Cones logo on its exterior. The business continues to draw attention with its unique dessert offerings.
Volunteer Pat Howe stocks shelves for food distribution at His House. The ministry distributes food to the community on Mondays and Thursdays.
Photo by LORELAI CURTIS
Photo by ELENA KALLENBACH
Photo by EDGAR CARDIEL
Dr. Laurie Diles publishes new textbook
ABBY DAVIDSON features editor
Professor of communication
Dr. Laurie Diles recently wrote a textbook for the communication principles class, which every student in the program is required to take. She began writing material for the book while helping her students condense class content in the fall of 2024. Later that fall, she received an email from a Christian division of the textbook company Kendall Hunt.
“I had gotten emails from them before, asking if I had a textbook I would like to publish,” Diles said. “I was like, ‘no, I don’t,’ but then I thought, ‘You know, I am writing material. Let me see what they have to say.’”
From then on, Diles began writing her drafts and editing them on a set schedule she made for herself to complete the material by the company’s deadlines. She finished writing the book in the spring of 2025, and it was first used on the international program’s trip to Greece in August, where students took a two-week communication principles course.
Junior Addie Edwards was on the trip and shared her experience with using the textbook.
“I had never taken a course where we used a textbook written by the professor, so I was initially hesitant,” Edwards said. “Yet, this enhanced the course overall because it was obvious that [Diles] had a deep connection to the material and it made the transition from textbook material to lecture content seamless.”
The textbook is being used this semester in all COMM 1010 classes taught by various communication professors. Junior Rochelle Reese is taking one of these classes now and has enjoyed using the new textbook.
“The textbook is one of the most to-thepoint, no-nonsense textbooks I have ever read,” Reese said. “It makes concepts that could be easily overcomplicated simple and really easy to understand. I just genuinely enjoy reading it.”

When writing the text, Diles had several goals in mind to ensure that students understood the importance of communication, especially through a Christian lens.
“Other textbooks were bringing in things that I did not want to deal with, and of course, they dealt not at all with Christianity,” Diles said. “I was able to make my textbook more Christian-oriented and to think of the people we talk about, talk to, think of and communicate with as our neighbors in a Christian way.”
Diles also includes parts of her personal experience throughout the book, recalling her various missionary assignments in Brazil and the Czech Republic, as well as her extensive field experience.
“In reading her book, you can practically hear her expertise through her writing,”
Edwards said. “Her knowledge, real-world experience and years of teaching culminate to create a textbook that is insightful and engaging.”
Reese also noted that Diles’s personal experience was evident throughout the text.
“This textbook is my first impression of what
I
Diles is like,”
tell when she talks about her experience on the mission field just how much she cares so deeply about everything she does and everyone she interacts with.”
While students can see Diles’s personal experiences in the text, the main goal was to make communication accessible and practical for everyone who reads the material.
“I did not say anything in the book that had not been said before,” Diles said. “But I do think that simplifying it helps people to see that this is something practical, this is something they can use.”
Honors students showcase research at national conference
CLARA KERNODLE assitant copy editor
The Harding Honors College sent two students and two faculty members to the National Collegiate Honors Conference in San Diego last week. Senior interdisciplinary studies major Camille Bewley and senior psychology major Emma Rosengartner presented their honors capstone projects as part of the undergraduate program at the conference, which took place Nov. 6-9.
Dr. Jaime Murphy, an Honors Senior Faculty Fellow and associate professor in the Department of Chemistry and Biochemistry, attended the conference.
“The Harding Honors College has been involved in the National Collegiate Honors Council for a long time,” Murphy said. “I’ve gone to this conference for three years. It’s a massive conference.”
Murphy described the application and selection process on Harding’s end.
“For anyone who does their Honors Capstone proposal in the fall of their junior year, I open it up for them to apply in the spring, and that way they have something to present in the fall of their senior year,” Murphy said. “It’s an open invitation for those students to apply, and we had just two spots this year, because San Diego meant flying and hotel costs.”
Bewley’s project is titled “In the Shadow


“It’s a great resource for students to present their work, but it’s also a great resource for
students to see the work of other students, plus other staff and faculty from honors programs at other universities,” Bewley said. “It’s the largest collective of honors programs in the nation; almost every single university that is accredited and has an honors program is invited to the conference.”
Bewley and Rosengartner presented their projects from poster boards, alongside other undergraduate students.
“I stood and presented for two hours on Saturday,” Bewley said. “I got really good feedback on my research.” Rosengartner’s project is titled “Cultural Perspectives on Work-Life Balance: Strategies for Enhancing Well Being.” She valued the conference’s opportunities.
“I went to a presentation on turning leadership into partnership,” Rosengartner said. “My favorite part of the conference was the networking events where I got to meet students from other colleges and share our passions with one another.”
The group also enjoyed the city of San Diego.
“We had some free time, and we got to walk the bayfront walkway all the way through Seafront Village and went to Kansas City Barbecue, which is where some of ‘Top Gun’ was filmed,” Bewley said.
The Bison Crossword and Connections


Senior honors student Camille Bewley presents her capstone research to conference attendees. The research conference took place in San Francisco during the first week of November.
Dr. Laurie Diles poses with her new textbook “Communication Principles and Practices.” The textbook was published in the summer of 2025.
Photo provided by CAMILLE BEWLEY
Photo by JADE DULIN
Professor
Reece said. “But
can
of Justice: How Batman Balances Major Ethical Theories and Demonstrates the Pursuit of Ideal Justice.” She appreciated the opportunity to attend and learn from
By JACOB BRANSON
peers and professors coming from schools across the country.

PART-TIME AND FULL-TIME POSITIONS AVAILABLE




Capstone Treatment Center works with young men ages 14-28 struggling with a wide range of hurts, struggles, compulsions, addictions and other self-destructive behaviors. The primary duty of Support Staff at Capstone is to ensure the safety, care, and well being of clients residing on campus. This role offers the unique opportunity to mentor, encourage, and support young men that are struggling and provide a positive example during their time at treatment.
Visit capstonetreatmentcenter.com to fill out your online application.
3B puzzles key:

